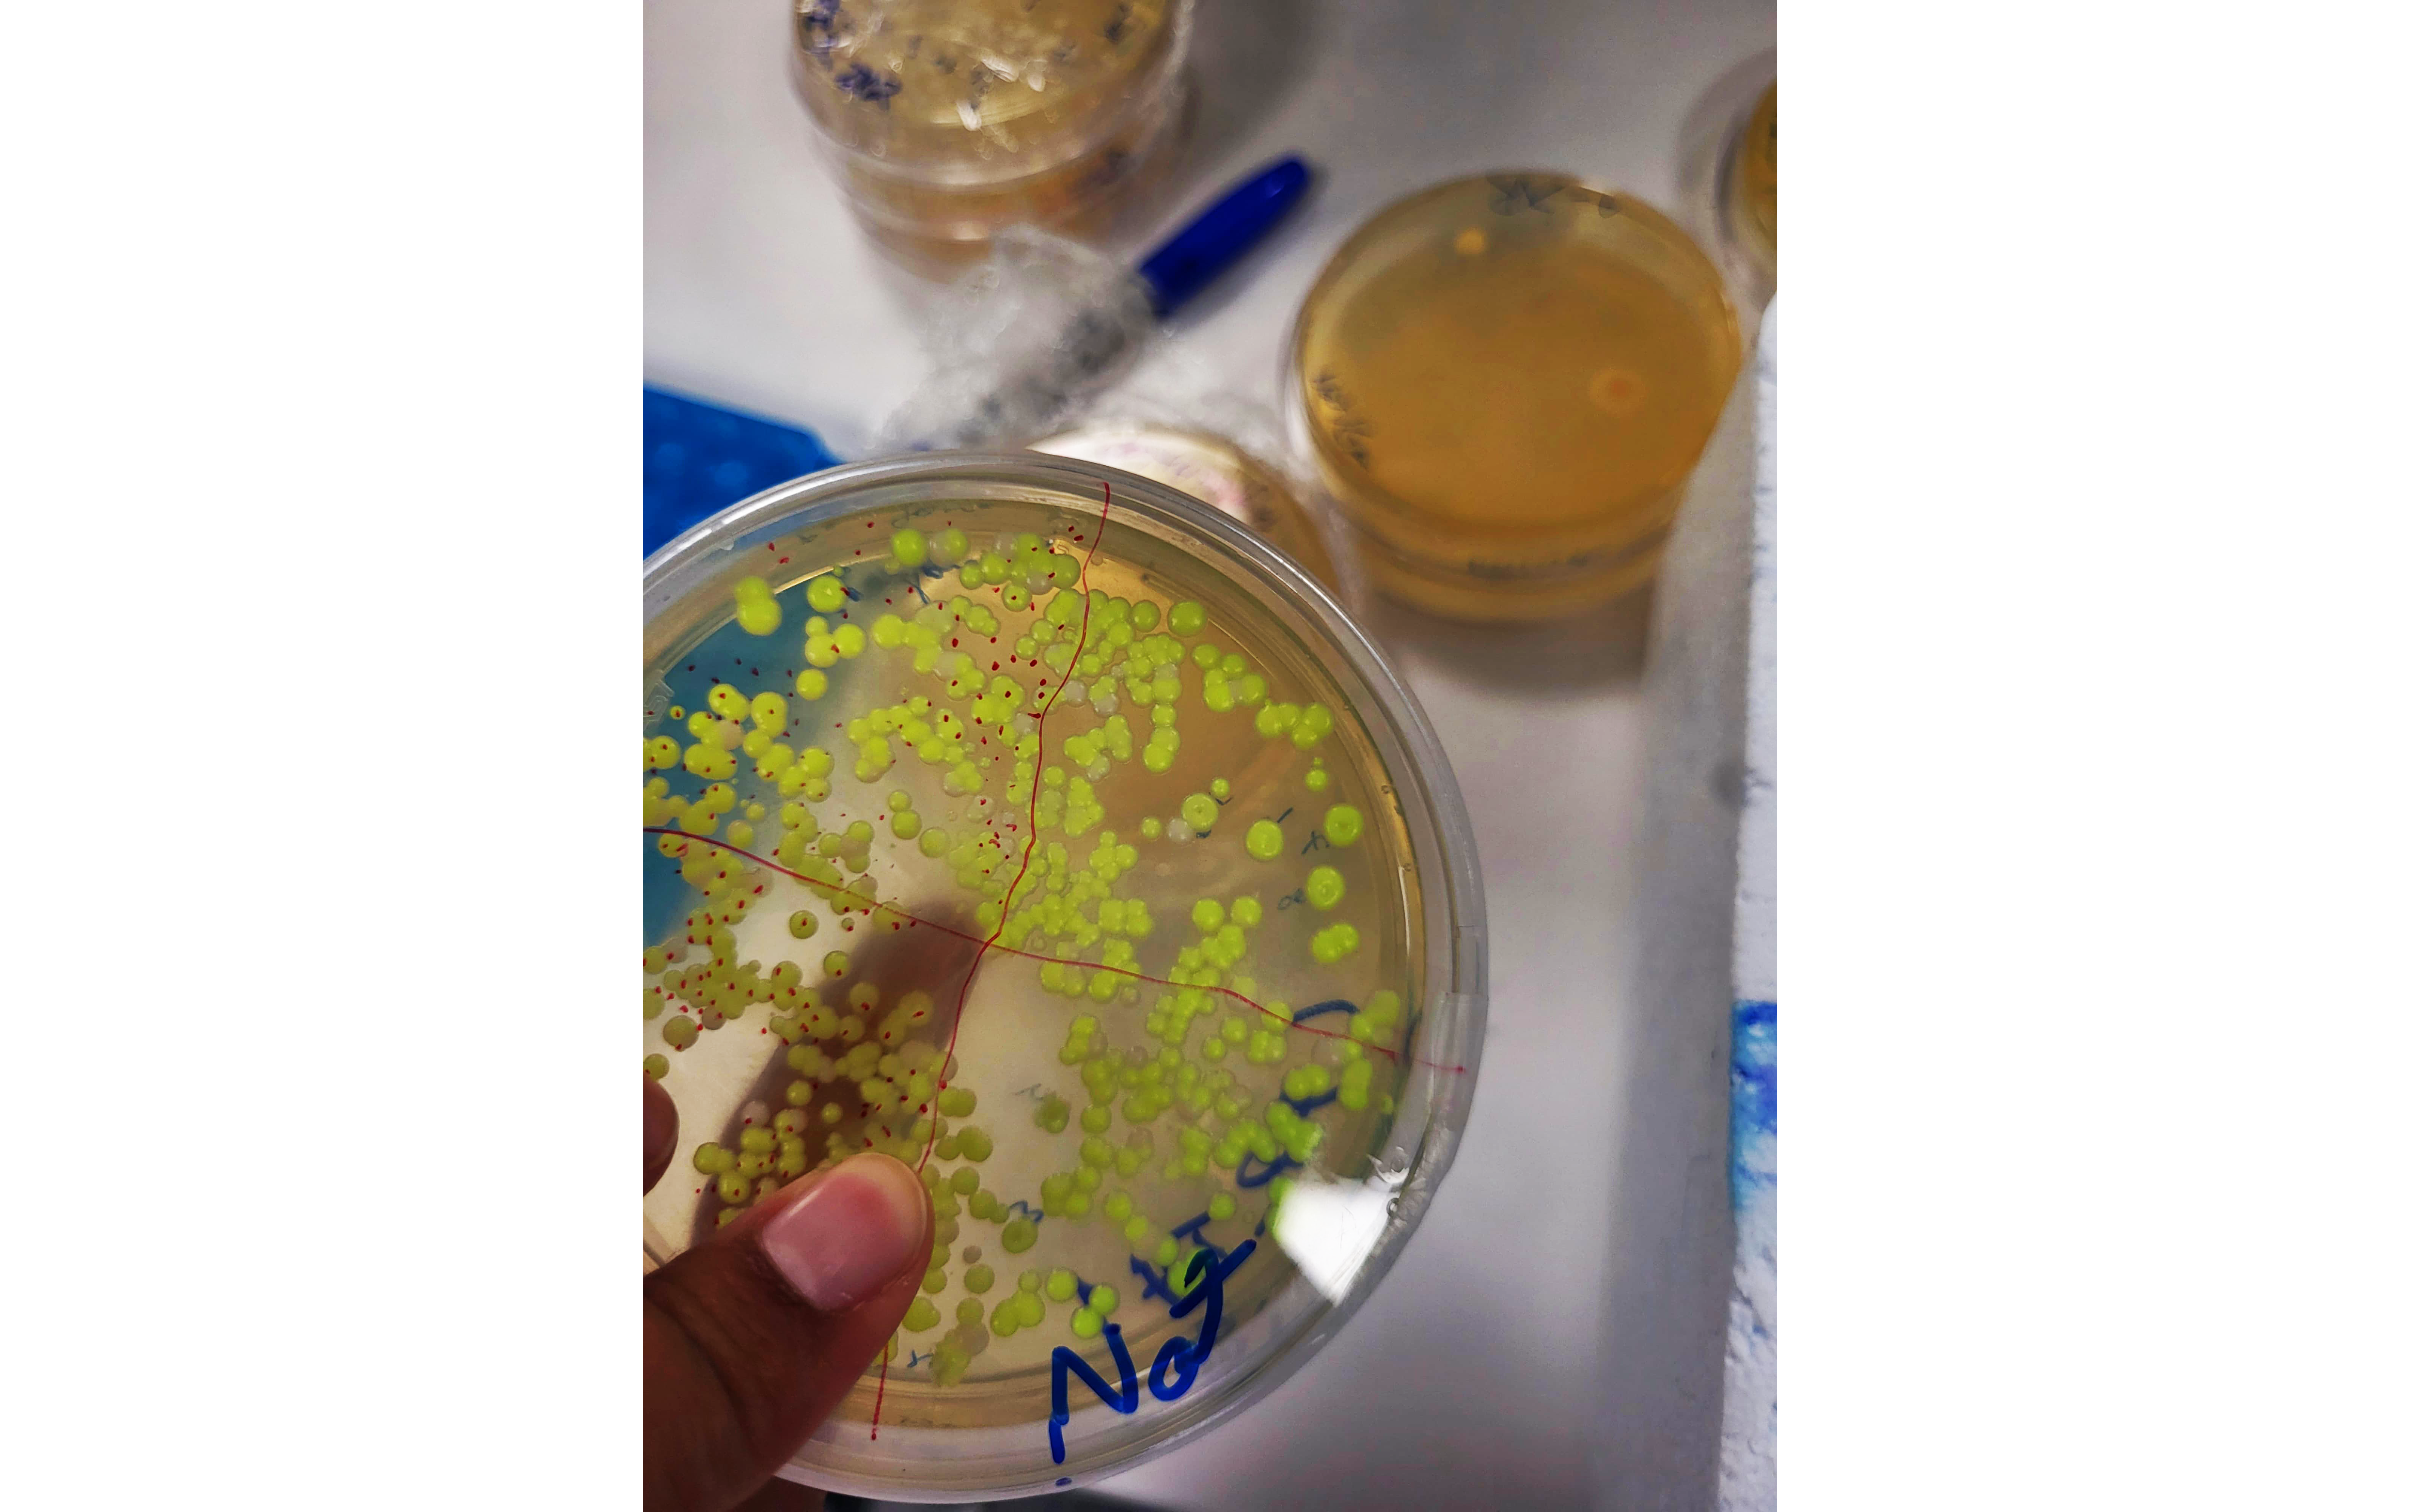

Julia Gnägi used the summer break to complete an IAESTE internship.
The SENAI Innovation Institute in Rio de Janeiro, Brazil, offered her an interesting research environment.
Field of study: BSc Bioanalytics and Cell Biology
Stay abroad: IAESTE internship
Host institution: SENAI Innovation Institute
Semester: Summer 2024
What made you decide, what motivated you to go abroad?
I had always wanted to do an exchange in another country because I believe it's the best way to immerse myself in a new culture and meet new people. However, I hadn’t pursued it before because it’s usually costly and challenging to organize. With support from IAESTE and the knowledge that I would earn enough to live in Brazil, I felt confident enough to go.
Why did you choose your host institution/country?
I chose Brazil because I’m part Brazilian and have regularly visited the country, but I’d never had the chance to really explore it. Usually, my trips were focused on family visits. This time, I wanted to see other places and meet new people. Brazil has so much to offer, and this was my chance to experience a bit of it.
What does a typical day at the host institution look like?
A typical workday for me involved a lot of PCR and gel electrophoresis. The most interesting part, though, was writing the report because that’s where I learned the most about CRISPR/Cas. I was fortunate to have very knowledgeable colleagues who were always willing to answer my questions. This was what I appreciated most about my internship; the people at SENAI truly took the time to teach me and make me feel at home.
When traveling, every day was different, but I spent a lot of time at beaches. Since I wanted to make the most of my time in Brazil, traveling usually meant very little sleep. But this allowed me to see Av. Paulista, Cristo Redentor, and the bustling markets in Feira de Santana. I tried all kinds of different foods and admired handmade products. The best part, though, was meeting so many funny, kind, and inspiring people.
Tell us about your research and your research findings during your residency.
I focused on understanding and applying CRISPR-Cas9 genome editing technology. The primary goal was to assemble donor and guide RNA (gRNA) plasmids in Saccharomyces cerevisiae (S. cerevisiae), using the green fluorescent protein (GFP) as a marker to determine successful assembly.
Throughout the research, I applied various lab techniques such as PCR, electrophoresis, yeast transformation by the LiAc method, and flow cytometry. While I successfully assembled both the donor and gRNA plasmids, the attempt to edit the yeast genome with CRISPR was not fully successful. It’s possible that the DNA was cleaved, but the donor didn’t properly anneal to the DNA. The exact reason for this outcome remains unclear.
Despite this, the project provided valuable insights into the complexities of plasmid assembly, recombination, and the challenges associated with precise genomic editing in yeast. The research findings highlighted areas for potential improvement, particularly in increasing the efficiency of CRISPR-based genome editing.
What surprised you the most about your stay abroad?
Since I already knew a lot about Brazilian culture, I wasn’t really surprised by much. However, I was reminded of how distinct each state is and how diverse the Brazilian people are. Despite these differences, they all share a common Brazilian identity.
I also found it fun to see how the other exchange students experienced Brazil so differently from me. They helped me see things I’d never thought twice about in a new light.
What tip would you like to give to future exchange students.
Document everything every chance you get. You’ll experience so much in such a short time, and there’s no way you’ll remember everything. So, make it a habit to keep track as it happens. A small, flexible journal fits anywhere and makes it easy to jot things down!